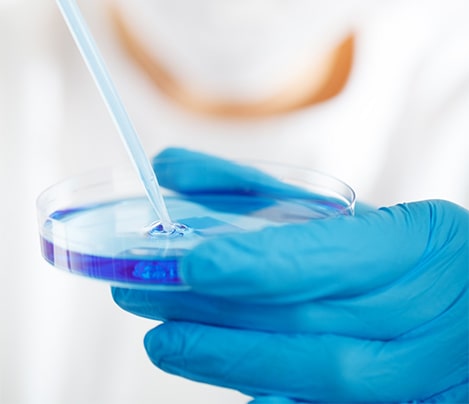
A blue-gloved hand pipetting blue liquid into a petri dish.

Plus Find Out The 5 Biggest Myths About Aging that keep you looking and feeling older in This FREE Masterclass
Sign up NOW to watch the free masterclass
Now playing free for a limited time

Your stop button for aging
Men and Women over 40:
Press Your Body’s Hidden Anti-Aging 'Button' To Double Your Energy, Clear Brain Fog And Turn Back The Clock 10 Years
Plus Find Out The 5 Biggest Myths About Aging that keep you looking and feeling older in This FREE Masterclass
Sign up NOW to watch the free masterclass
Now Playing FREE For A Limited
Time
(usually $500)!
Plus Find Out The 5 Biggest Myths About Aging that keep you looking and feeling older in This FREE Masterclass
Sign up NOW to watch the free masterclass
Now Playing FREE For A Limited
Time (usually $500)!

FREE BONUS: When you register today for free, you'll also get our new exclusive guide:
5 Anti-Inflammatory Drinks You Can Sip All Day Long (Valued at $27)
- Why inflammation might be aging you faster than cigarettes or alcohol, and the natural drinks that instantly calm inflammation (no medications or doctor visits needed!) (page 5)
- Harvard APPROVED: One of the best fruits you can eat to reduce inflammation. (Sprinkle this on your fresh morning orange juice and watch how your body feels!) (page 8)
- BETTER THAN PROTEIN POWDER! Try this delicious drink after a workout to speed up recovery, prevent muscle soreness, and even reduce inflammation! (page 12)
FREE BONUS: When you register today for free, you'll also get our new exclusive guide:
5 Anti-Inflammatory Drinks You Can Sip All Day Long (Valued at $27)

- Why inflammation might be aging you faster than cigarettes or alcohol, and the natural drinks that instantly calm inflammation (no medications or doctor visits needed!) (page 5)
- Harvard APPROVED: One of the best fruits you can eat to reduce inflammation. (Sprinkle this on your fresh morning orange juice and watch how your body feels!) (page 8)
- BETTER THAN PROTEIN POWDER! Try this delicious drink after a workout to speed up recovery, prevent muscle soreness, and even reduce inflammation! (page 12)
Is there a way to age slower and maintain your ability to be active, sharp-minded, and energetic well into your 40s, 50s, 60s 70s, 80s, or beyond?
And how could you delay the onset of chronic disease by almost a decade?
Thanks to a little known breakthrough in the aging and chronic disease field, Dr. Rosedale shares the things you can do to impact your health and longevity:
- Age is just a number: Why biological aging and chronological aging are different… And how you unknowingly age incorrectly by accelerating our biological aging
- Are you aging too fast? The state of these 3 key hormones can predict how fast you’re aging
- Why this little-known “CEO enzyme of longevity” controls how fast you age and if it can delay the onset of aging signs, like wrinkles, weight gain, skin issues, grey hair and more
- Why controlling this enzyme may help your body stay away from gut inflammation, diabetes, dementia, heart disease, osteoporosis and more
- How to keep your body in a youthful state of cell repair with “the CEO enzyme of longevity”... and why cancer patients have this enzyme going haywire
- The 5 steps that change the game when it comes to keeping your cells, skin and organs young. Also: Discover what natural ingredients will elevate “the CEO enzyme of longevity” and what foods you should avoid
- Revealing “the longevity way of eating” that can help you stay active and enjoy life by keeping your cells in a youthful state, well into your 40s, 50s, 60s, 70s, 80s and beyond
- The 5 Biggest Aging MYTHS behind memory loss, obesity, diabetes, osteoporosis and heart disease...
- The dietary change that extended the lifespan of rodents by 33% and how this discovery can help you live longer
- The quickest and easiest way to get slimmer and decrease your biological age, at any age (even if you feel you’re aging prematurely)
Sign up NOW to watch the free masterclass
Now Playing FREE For A
Limited
Time

Dr. Ron Rosedale
Dr. Ron Rosedale is a world-renowned expert in anti-aging, nutrition, diabetes, and metabolic disease.
His groundbreaking clinics, programs and books have helped thousands of patients recover from age-related diseases.

My life’s mission is to help our nation reverse the epidemic of incorrect aging.
See What
Celebrities Are Saying
About This Masterclass

See What Celebrities Are Saying About This Masterclass
Sign up NOW to watch the free masterclass
Now Playing FREE For A
Limited
Time

Ronn Moss
ACTOR, THE BOLD AND THE BEAUTIFUL

This Masterclass features one of the top longevity experts in the world, Dr. Ron Rosedale. Dr. Ron reveals a profound medical breakthrough in the field of aging that people like you and me should hear. You will find it really eye-opening. Don't miss the opportunity!
Sofia Milos
ACTRESS, CSI MIAMI

I just finished watching the Masterclass by Dr. Ron Rosedale and I just have to share my enthusiasm with you and support for what he says and shares. It’s such valuable information. We can slow down the biological clock by learning from people like Dr. Ron Rosedale, so I invite you to watch the Masterclass, give yourself some love and it’s absolutely free.


Sofia Milos
ACTRESS, CSI MIAMI

I just finished watching the Masterclass by Dr. Ron Rosedale and I just have to share my enthusiasm with you and support for what he says and shares. It’s such valuable information. We can slow down the biological clock by learning from people like Dr. Ron Rosedale, so I invite you to watch the Masterclass, give yourself some love and it’s absolutely free.

Louis Mandylor
ACTOR, MY BIG FAT GREEK WEDDING

I was blown away by the fascinating information in the ‘CEO of Aging’ Masterclass. I’ve never heard of the CEO enzyme of longevity before, and now I can’t stop thinking about how this can benefit me, my lifestyle and my exercise habits. I highly recommend it!
Sign up NOW to watch the free masterclass
Now Playing FREE For A
Limited
Time

The rate of aging can be significantly altered by what we eat, especially the amount of macronutrients including carbohydrates, fat, and protein.
And in a little bit I will tell you about the diet I proposed 30 years ago that can help with slowing down aging significantly”
Dr. Ron Rosedale

add to your calendar
Take this opportunity for some me-time and clear your calendar in advance

90 minutes
Block around 90 minutes for this masterclass without any distractions

share this masterclass
Everyone has the right to know how to age correctly and gracefully

Your Host:
Stefan Apostolov is a lifestyle coach award-winning film filmmaker specializing in highly impactful video content.
Throughout his life, Stefan focused on building healthy habits and adopting a good nutrition and exercise regime.
He is the CEO of Zonia, a video-streaming platform that helps people change their life and reach their highest potential, both physically and mentally.


